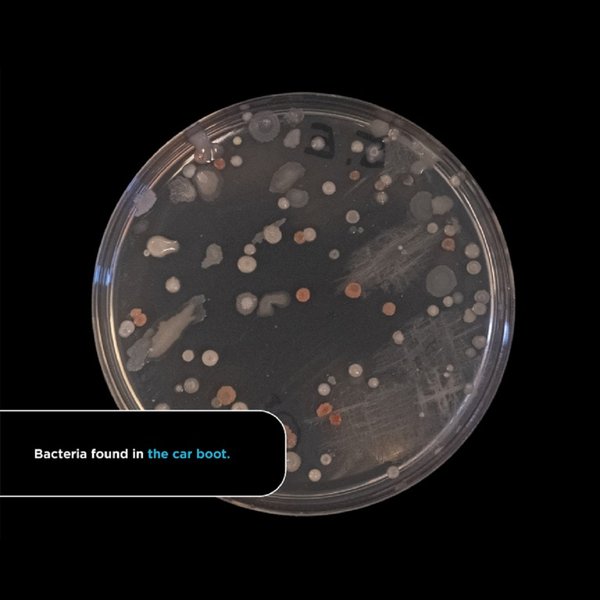
Бактерии в авто, салон автомобиля, концентрация бактерий, бактерии в салоне авто, бактерии на сиденье водителя
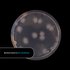
Бактерии в авто, салон автомобиля, концентрация бактерий, бактерии в салоне авто, бактерии на сиденье водителя

Салон автомобиля оказался грязнее туалета – исследование

Автомобиль внутри буквально кишит бактериями. Больше всего их обнаружили в багажнике.
Салон автомобиля – настоящий сборник бактерий. К такому заключению пришли ученые из школы бионаук Университета Астона в британском Бирмингеме по результатам исследования. Его результаты опубликовал сайт Scrap Car Comparison.
В рамках исследования ученые взяли образцы из салонов пяти автомобилей разного возраста, причем самой новой машине – всего два года. Для сравнения также были взяты пробы с сиденья унитаза в двух туалетных комнатах.
Оказалось, что концентрация бактерий в автомобиле больше, чем в туалете. Мало того, в салоне и багажнике авто выявлены фекальные бактерии подобно тем, которые накопляются на унитазе. Больше всего бактерий обнаружили в багажнике – 1425 разных видов.
Самые загрязненные места салона автомобиля:
- Багажник – 1425 видов бактерий
- Водительское сиденье – 649
- Рычаг КПП – 407
- Заднее сиденье – 323
- Передняя панель – 317
Удивительно, но обод руля оказался относительно чистым, хотя именно его водитель чаще всего касается руками. Руководитель исследования доктор Джонатан Кокс объясняет это тем, что в условиях эпидемии коронавируса водители стали чаще протирать руль антисептиками.
Важно
Также отмечено, что концентрация бактерий в салоне напрямую зависит от возраста автомобиля. В старых машинах она больше, то есть бактерии накапливаются со временем.
Ранее Фокус рассказывал об исследовании безопасности автомобилей. Бензиновые авто оказались в 60 раз опаснее электромобилей.